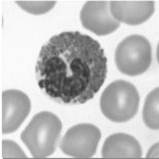

|
1. Sistema imunitárioOs organismos mais complexos, como os animais vertebrados, possuem um verdadeiro sistema imunitário, constituído por diversos tipos de células e órgão, que protegem o organismo contra potenciais agentes agressores biológicos (microrganismos) ou químicos (toxinas). Adicionalmente, o sistema imunitário é ainda responsável pela destruição de células envelhecidas ou anormais (cancerosas) do próprio organismo. Os agentes biológicos capazes de causar doenças denominam-se organismos patogénicos e podem ser vírus, bactérias, fungos, protozoários ou mesmo animais parasitas (fig. 1). Os organismos patogénicos podem entrar no corpo dos seres vivos através do ar, da água, dos alimentos ou através de lesões da pele ou das mucosas. Os vírus e as bactérias são os organismos patogénicos mais frequentes. Estes organismos causam infecções de forma distinta, devido às suas características biológicas. Os vírus são seres acelulares, genericamente, são constituídos por um invólucro protector de natureza proteica e por material genético (DNA ou RNA). Alguns vírus são ainda rodeados por uma membrana de natureza lipídica. Os vírus são parasitas intracelulares obrigatórios – só manifestam características vitais no interior de células vivas por eles invadidas. Para se multiplicarem, os vírus têm de introduzir o seu material genético numa célula e assumir o comando do seu metabolismo. O DNA do vírus é replicado, e a transcrição e tradução de genes virais permite a formação de novas cápsulas protectoras, estes podem abandonar a célula hospedeira por um processo semelhante à exocitose mas, frequentemente, multiplicam-se de tal forma que provocam o seu rebentamento.
Fig2. Multiplicação de vírus Ao contrário dos vírus, as bactérias são seres vivos, sendo, por isso, capazes de se reproduzirem de forma autónoma. As bactérias são células procariontes (o Dna forma uma molécula principal, geralmente sem invólucro nuclear; podem existir pequenos anéis de Dna com genes acessórios – plasmídeos; não possuem organelos membranares, mas possuem ribossomas e todas as estruturas necessárias às biossínteses e às transformações energéticas). Muitas bactérias coabitam em verdadeira cooperação com o organismo humano (como a flora bacteriana do intestino), enquanto outras, vivem como parasitas provocando diversas doenças (algumas produzem toxinas potentes e outras multiplicam-se no interior das células, destruindo-as) (imagem da página 187). O sistema imunitário é formado por órgãos linfóides, vasos linfíticos e por células efectoras (ex. leucócitos, plasmócitos, macrófagos) Existem dois tipos de órgãos linfóides: . Órgãos ou estruturas onde são produzidos e maturados os leucócitos (timo e medula óssea). Este tipo de órgão é chamado de órgãos linfóides primários. . Órgãos envolvidos na captura e destruição de agentes agressores externos (adenóides, amígdalas, gânglios linfáticos, baço, apêndice e tecido linfático associado a mucosas). Este tipo de órgão é chamado de órgãos linfóides secundários. O sangue é um componente importante para o sistema imunitário pois é nele que os sistemas de defesa podem percorrer o nosso organismo, este é constituído por plasma, leucócitos ou glóbulos brancos, hemácias ou glóbulos vermelhos e plaquetas. O plasma é um líquido de cor meia amarelada (constituído principalmente por água e proteínas) onde estão suspensos todos os outros constituintes do sangue. As hemácias são células simples, sem núcleo e com forma achatada, são produzidas no baço e na medula óssea (4 a 6 milhões/mm3). Têm a cor vermelha devido à hemoglobina, esta substância permite-lhes transportar o oxigénio e algum dióxido de carbono. Os glóbulos vermelhos são os constituintes de maior percentagem no sangue. As plaquetas são fragmentos celulares, de pequena dimensão, com a forma ovóide e sem núcleo, são responsáveis pela coagulação do sangue. Os leucócitos são células com núcleo, de maiores dimensões que os glóbulos vermelhos, tal como estes são produzidos no baço e na medula óssea, mas também nos gânglios linfáticos (4 a 10 mil/mm3). Têm uma função de defesa do organismo, e para cumprirem esta função existem diferentes tipos de leucócitos: . Neutrófilos (fig3) – São granulócitos (classificação feita com base na presença ou ausência de granulações no citoplasma) com núcleo polilobado e constituem 60% a 70% de todos os leucócitos (3000 a 7000/mm3). Realizam a fagocitose e são os primeiros a chegar aos tecidos infectados, atraídos por quimiotaxia (os basófilos produzem e libertam substâncias capazes de interagir com outros glóbulos brancos do sangue, atraindo-os para o local de libertação desses compostos químicos).
Fig3. Neutrófilo Fig4. Basófilo . Basófilos (fig4) – São granulócitos com núcleo volumoso de forma irregular, sendo ligeiramente mais pequenos que os neutrófilos, que constituem menos de 2 % de todos os leucócitos (20 a 50/mm3). Quando activados libertam substâncias, como a histamina, que intervêm na resposta imunitária, podem realizar a fagocitose, mas de forma muito lenta. . Eosinófilos (fig5) – São granulócitos com núcleo bilobado, têm dimensões semelhantes aos basófilos, constituem cerca de 2% de todos os leucócitos (100 a 400/mm3). Têm actividade fagocítica limitada, particularmente dirigida a parasitas. Reduzem a reacção inflamatória, pela produção de enzimas que degradam as substâncias químicas produzidas pelos basófilos.
Fig5. Eusinófilo Fig6. Monócito . Monócitos (fig6) – Agranulócitos de pequenas dimensões com núcleo em forma de ferradura, constituem cerca de 5% de todos os leucócitos (100 a 700/mm3). Circulam no sangue durante poucas horas e depois migram para os tecidos, aumentam de tamanho e transformam-se em macrófagos (células fagocitárias de grandes dimensões, que vivem muito tempo). . Linfócitos (fig7) – Agranulócitos com núcleo esférico e volumoso, constituem cerca de 30 % de todos os leucócitos (1500 a 3000/mm3). A maioria dos linfócitos pertence a um dos seguintes grupos: linfócitos B ou linfócitos T. Os linfócitos B, quando activados diferenciam-se em plasmócitos, que produzem anticorpos, e em células de memória. Os linfócitos T contribuem para a activação dos linfócitos B e destroem agentes patogénicos. Considera-se ainda a existência de um terceiro grupo de linfócitos – células NK (natural killer cells) que têm como função destruir células infectadas por vírus e células cancerosas.
Fig7. Linfócitos O sistema imunitário consegue reconhecer os organismos que lhe são estranhos, através de glicoproteínas inseridas nas membranas das células, e que identificam o que é próprio do organismo e o que não é, uma vez que cada ser vivo é incomparável do ponto de vista bioquímico, essas glicoproteínas que identificam cada microrganismo são marcadores celulares (codificado pelo conjunto de genes ligados ao cromossoma 6 e constituem o complexo maior de histocompatibilidade – MHC). Mas, o sistema imunitário faz mais do que distinguir o que é “próprio” de “estranho”, ele reage num sistema de causa – efeito, isto é quando detecta marcadores diferentes do sistema ou quando detecta sinais de perigo (ex: lesões que conduzem à destruição de tecidos e células), desencadeia uma resposta do sistema. Para cumprir com a sua função de defesa, o sistema imunitário possui dois tipos de, mecanismos: mecanismos de defesa não específicos (também conhecidos por imunidade inata) e mecanismos de defesa específico (também conhecidos por imunidade adquirida). 1.1 Mecanismos de Defesa Não Específicos A defesa não específica incluí o conjunto de processos através dos quais o organismo previne a entrada de agentes estranhos, reconhecendo-os e destruindo-os quando essa entrada acontece. A resposta do organismo é sempre a mesma, qualquer que seja o agente invasor e qualquer que seja o número de vezes que este contacta com o organismo. Como exemplo deste mecanismo temos as barreiras físicas e secreções, fagocitose, resposta inflamatória e o interferão. As barreiras físicas e secreções previnem a entrada de agentes estranhos no organismo: . A pele e as mucosas, quando intactas, não permitem a entrada de agentes patogénicos; . As secreções das glândulas sebáceas e sudoríparas inibem o desenvolvimento da maior parte das bactérias; . A lisozima, presente nas lágrimas e na saliva, o ácido clorídrico produzido no estômago e o muco do revestimento das vias respiratórias destroem os microrganismos e/ou expulsam-nos do organismo. A fagocitose consiste na ingestão de partículas (como, por exemplo, os microrganismos) e é realizada por alguns tipos de leucócitos (sobretudo neutrófilos e macrófagos), este processo actuam geralmente ligado a outros mecanismos de defesa. A resposta inflamatória é uma sequência complexa de acontecimentos que ocorre quando agentes patogénicos conseguem ultrapassar as barreiras físicas de defesa do organismo. Esta resposta pode ser: Local (fig.8) – consiste na libertação de histaminas e outros mediadores químicos, por células lesionadas (ex. basófilos), no tecido contaminado por agentes patogénicos. A libertação de histamina leva a um aumento de permeabilidade dos vasos sanguíneos e a uma vasodilatação (como consequência aumenta o fluxo sanguíneo no local e uma maior quantidade de fluido intersticial passa para os tecidos envolventes; a zona atingida manifesta rubor, calor e edema; a dor que acompanha a reacção inflamatória é causada pela acção de substâncias químicas nas terminações nervosas locais e pela distensão dos tecidos). Os neutrófilos e os monócitos são atraídos por quimiotaxia, deixam os vasos sanguíneos por diapedese (migração dos leucócitos dos capilares sanguíneos para os tecidos, através de poros existentes entre as células das paredes dos capilares) e dirigem-se aos tecidos infectados, começando a realizar a fagocitose dos agentes patogénicos. Os neutrófilos são os primeiros a chegar, seguidos dos monócitos que se diferenciam em macrófagos. Os macrófagos fagocitam os agentes patogénicos e os seus produtos, os neutrófilos destruídos no processo e as células danificadas. O pus que se acumula no local da infecção é formado por microrganismos e fagócitos mortos e por proteínas e fluidos que saíram dos vasos sanguíneos.
Fig8. Reacção inflamatória local Deste tipo de mecanismos tem como efeitos secundários vermelhidão, calor e inchaço. Sistémica – Quando os agentes patogénicos são particularmente agressivos, é accionada uma reacção inflamatória sistémica, que ocorre em várias parte do organismo, o que leva ao aumento do número de leucócitos (que são produzidos em maiores quantidades pela medula óssea, que é estimulada através de substâncias químicas produzidas pelas células danificadas) em circulação. Um dos efeitos secundários deste mecanismo de defesa é a febre. A febre pode ser desencadeada pelos agentes patogénicos ou pelos leucócitos que produzem substâncias que actuam sobre o hipotálamo e regulam a temperatura corporal para um valor mais alto (a febre moderada é benéfica dado que acelera as reacções do organismo estimulando a fagocitose e a reparação dos tecidos lesado; inibe a multiplicação de alguns microrganismos).
O interferão são proteínas produzidas por certas células atacadas por vírus que se difundem para células vizinhas, induzindo-as a produzir proteínas antivirais. Estas proteínas bloqueiam a replicação do vírus, limitando o seu alastramento.
Acção antiviral do interferão 1.2 Mecanismos de Defesa Específicos Todos os componentes moleculares que desencadeiam uma resposta específica são antigénios, podem ser moléculas superficiais de bactérias, vírus ou outros microrganismos, toxinas, produzidas por bactérias ou mesmo moléculas presentes no pólen, pêlo de animais e células de outras pessoas. As principais células que intervêm na defesa específica do organismo são os linfócitos B e os linfócitos T. Ambos os linfócitos se formam a partir de células estaminais da medula vermelha dos ossos, mas células precursoras do linfócito T migram para o timo, onde completam a sua migração, o contrário acontece com os linfócitos B que sofrem todas as transformações na medula óssea. Durante a maturação ambos os linfócitos (B e T) adquirem receptores superficiais, que são capazes de identificar um número quase infinito de moléculas estranhas ao organismo, tornando-se células imunocompetentes. Durante o processo de maturação, os linfócitos têm de adquirir a capacidade de distinguir o que é próprio do que é estranho ao organismo. Assim, os linfócitos que apresentam nas suas membranas receptoras para “antigénios” próprios, isto é moléculas que fazem parte do organismo, têm de ser eliminadas. O conjunto de linfócitos com receptores para um determinado antigénio constituem clones. Seguidamente, passam para a circulação sanguínea e linfática e encontram-se em grandes quantidade em órgãos do sistema linfático, como o baço ou os gânglios linfáticos. (imagem da página 200) A defesa específica inclui o conjunto de processos através dos quais o organismo reconhece os agentes invasores e os destrói de uma forma dirigida e eficaz. Ao contrário do que acontece com a defesa não específica, a resposta do organismo ao agente invasor melhora com a continuidade do ataque (verifica-se especificidade e memória). Como exemplo deste mecanismo temos a imunidade humoral e celular, memória imunitária e a imunização. A imunidade humoral é mediada por anticorpos que circulam no sangue e na linfa e que são produzidos após o reconhecimento do antigénio (moléculas que se encontram na superfície de agentes patogénicos) pelos linfócitos B. Quando existe esse contacto, os linfócitos que tem o receptor desse antigénio entram em divisão celular multiplicando o seu número. As novas células vão se dividir em dois grupos: células efectoras ou plasmócitos (que vão combater o “estranho”) e células – memória (células que ficam no sangue por longos períodos de tempo e que respondem rapidamente num segundo contacto com o mesmo antigénio). A defesa do organismo, através da imunidade humoral, envolve os seguintes acontecimentos: 1.Reconhecimento de determinantes antigénicos por linfócito B com receptores específicos; 2.Activação do clone de linfócito B, que entra em divisão celular; 3.Diferenciação, em plasmócitos (células produtoras de anticorpos, que são libertados no sangue e na linfa), de parte das células do clone de linfócito B activado; diferenciação de outra parte linfócitos B de memória (são células que ficam no sangue por longos períodos de tempo e que respondem rapidamente num segundo contacto com o mesmo antigénio) 4.Interacção dos anticorpos com o antigénio 5.Destruição dos antigénios por fagocitose 6.Morte dos plasmócitos e degradação dos anticorpos, após a destruição do antigénio, diminuindo a sua concentração no sangue. As células memória continuam activas.
Os anticorpos pertencem a um grupo de proteínas globulares designadas imunoglobulinas. Apresentam estrutura em forma de “Y”, constituída por quatro cadeias polipeptídicas, duas cadeias pesadas e duas cadeias leves. As cadeias polipeptídicas possuem uma região constante, muito semelhante em todas as imunoglobulinas, e uma região variável.
Os anticorpos possuem uma região cuja sequencia de aminoácidos é muito semelhante em todos eles, mesmo em anticorpos de espécies diferentes. Esta região é designada por região constante, participa na interacção com outros elementos do sistema imunitário e determina a classe a que pertence a imunoglobulina. Na porção terminal das cadeias leves e pesadas, existe uma região cuja sequência de aminoácidos é distinta e própria de cada tipo de anticorpo, que se designa região variável. A sequência de aminoácidos da região variável confere a elevada especificidade que caracteriza os anticorpos. Por um lado, esta sequência determina se esse antigénio tem, ou não, uma estrutura complementar de um determinado antigénio e, por outro lado, permite o estabelecimento de ligações (pontes de hidrogénio e forças electrostáticas) entre o antigénio e o anticorpo. Dada a sua forma em “Y”, cada anticorpo apresenta duas regiões variáveis e, por isso, dois locais de ligação ao antigénio. Existem vários tipos de imunoglobulinas (Ig):
(página 204)
Quando os anticorpos se ligam aos antigénios formam o complexo antigénio - anticorpo, este complexo pode agir de diferentes formas: . Neutralização – os anticorpos ligam-se aos antigénios, neutralizando-os. A neutralização dos vírus resulta da ligação dos anticorpos a moléculas que são fundamentais para que os vírus possam infectar as células. No caso das bactérias, os anticorpos cobrem a sua superfície, até que sejam eliminadas por células fagocitárias. . Aglutinação – os anticorpos ligam-se aos determinantes antigénicos, formando complexos de grandes dimensões, que são rapidamente fagocitados por macrófagos. . Precipitação – é um processo semelhante à aglutinação, mas realiza-se com moléculas dissolvidas nos fluidos corporais, como as toxinas. Os anticorpos formam complexos insolúveis que são removidos por fagócitos, isto é, a ligação de moléculas solúveis do antigénio, formando complexos insolúveis que se precipitam. . Activação do sistema de complemento – o complexo antigénio – anticorpo activa a primeira proteína do complemento, dando início a uma série de reacções sucessivas de activação. Algumas proteínas do complemento produzem poros na membrana das bactérias, conduzindo à sua lise. Outras proteínas do complemento desencadeiam outros processos, como a vasodilatação e a quimiotaxia. . Estimulação da fagocitose – Os macrófagos possuem receptores que reconhecem os anticorpos (sobretudo a IgG) ligados aos antigénios, sendo estimulados a realizar fagocitose. A imunidade celular é mediada pelos linfócitos T e é particularmente efectiva na defesa do organismo contra agentes patogénicos intracelulares, pela destruição de células infectadas e contra células cancerosas. É, também, responsável pela rejeição de enxertos e de transplantes. O processo de imunidade celular está dividido em 4 fases: 1.O processo tem início com a apresentação do antigénio aos linfócitos T. (as células apresentadoras podem ser macrófagos, que fagocitaram e processaram agentes patogénicos, podem ser linfócitos B, células infectadas, células cancerosas ou células de outro organismo). Como é que os macrófagos activam os linfócitos T? Após fagocitar e digerir os agentes patogénicos, formam-se fragmentos de moléculas com poder antigénico que são inseridas na membrana do macrófago. Assim, os macrófagos exibem na sua superfície o antigénio, apresentando-o aos linfócitos Th, que o reconhecem devido aos receptores específicos que possuem, ficando activados. 2.Depois de activados, os linfócitos T diferenciam-se em linfócitos Th ou linfócitos auxiliares (uma vez activados, libertam mediadores químicos (citoquinas) que estimulam a fagocitose, a produção de interferão e a produção de anticorpos pelos linfócitos B), linfócitos Tc ou citotóxicos (que desencadeiam uma reacção de lise celular) e em células memória.
3.Os linfócitos T citotóxicos ligam-se às células estranhas ou infectadas e libertam perforina, uma proteína que forma poros na membrana citoplasmática, provocando a lise celular.
4.Os linfócitos T de memória desencadeiam uma resposta mais rápida e vigorosa num segundo contacto com o mesmo antigénio.
O primeiro contacto do organismo com um antigénio origina uma resposta imunitária primária, durante a qual são activados linfócitos B e T que se diferenciam em células efectoras e células de memória. Eliminado o antigénio, as células efectoras desaparecem. As células memória permanecem no organismo e dão origem a uma resposta imunitária secundaria, mais rápida, intensa e prolongada, num segundo contacto com o mesmo antigénio. Esta propriedade designa-se memória imunitária (é específica para um determinado antigénio).
A imunidade pode desenvolver-se naturalmente ou pode ser induzida. A imunidade pode ser induzida através de vacinas (imunidade activa) ou através da administração directa de anticorpos específicos (imunidade passiva).
Uma vacina é uma solução preparada com antigénios tornados inofensivos (mortos ou atenuados ou toxinas inofensivas), a vacina desencadeia no organismo uma resposta imunitária primária e formam-se células de memória (imunidade activa – o efeito é permanente). Os soros são soluções que contêm anticorpos, retirados do plasma de indivíduos que já estiveram em contacto com esse antigénio (imunidade passiva – o efeito é temporário). Imagem da página 213 – IMPORTANTE 1.3 Desequilíbrios e Doenças O sistema imunitário pode revelar várias deficiências no seu funcionamento dando origem a desequilíbrios e doenças. Algumas doenças resultam da incapacidade do sistema imunitário responder com eficácia aos agentes que ameaçam o organismo e designam-se por imunodeficiências. Outras doenças resultam de uma reacção excessiva do sistema imunitário, ou hipersensibilidade, em relação a agentes estranho inócuos (inofensivos) ou aos próprios constituintes do organismo. Alergias As alergias são reacções de hipersensibilidade a certos antigénios ambientais, os alergénios. O pólen, ácaros, pó, esporos, pêlo de animais, certos produtos químicos e alimentares, por regra inofensivos, são alergénios comuns para algumas pessoas, desencadeando uma resposta aberrante do sistema imunitário. Algumas alergias podem conduzir a consequências graves com lesões de tecidos e/ou órgãos. Alergias – hipersensibilidade imediata Num primeiro contacto com o alergénio, os linfócitos B são estimulados e diferenciam-se em plasmócitos que produzem anticorpos específicos da classe IgE. Esses anticorpos ligam-se a mastócitos e basófilos, isto é, apesar de não se manifestarem sintomas ou sinais, os mastócitos e os basófilos ficam sensibilizados para esse antigénio. Num segundo contacto, o antigénio liga-se aos anticorpos IgE presentes na superfície dos mastócitos e basófilos (que estão sensibilizados) e estimula estas células a libertar grandes quantidades de histamina e outras substâncias inflamatórias. A histamina desencadeia uma reacção inflamatória intensa que é responsável pelos sintomas da alergia, como por exemplo, espirros, erupções cutâneas e contracção dos músculos das vias respiratórias.
Hipersensibilidade imediata Alergias - Hipersensibilidade tardia Este tipo de hipersensibilidade não inicia nas horas seguintes à exposição ao antigénio. Está associada a reacções imunitárias mediadas por células (imunidade celular) com respostas muito intensas dos linfócitos T e macrófagos que podem provocar lesões nos tecidos (ex. eczemas, granulomas, lesões cutâneas). Os eczemas de contacto, por exposição repetida a lixívia, cosméticos, cimento, tintas, metais, etc., enquadram-se nestas alergias. Algumas reacções alérgicas podem conduzir a um choque anafilático, que é provocado pela diminuição brusca da pressão arterial em consequência do aumento da permeabilidade dos vasos sanguíneos. Os sintomas das alergias podem ser tratados com medicamentos anti-histamínicos. O processo de sensibilização a um determinado alergénio não ocorre em todos os indivíduos. Alguns indivíduos vão sensibilizando progressivamente, á medida que têm vários contactos com o alergénio. Outros, porém, nunca desenvolvem mecanismo de hipersensibilidade para esse alergénio. Doenças auto-imune As doenças auto-imunes resultam de uma reacção de hipersensibilidade do sistema imunitário contra antigénios próprios (células ou tecidos do próprio organismo. Como já foi dito, durante o processo de maturação dos linfócitos, são eliminados aqueles que possuem receptores capazes de interpretar como estranho o que é próprio do organismo. Durante muito tempo pensou-se que este tipo de doenças estava relacionada com erros que faziam com que os linfócitos sensíveis aos antigénios do organismo não fossem eliminados, mas agora sabe-se que mesmo em indivíduos saudáveis é possível encontrar linfócitos sensíveis para o que é próprio do organismo. Contudo, este linfócitos não desenvolvem uma resposta auto-imune porque existem mecanismo reguladores que os bloqueiam. Existem vários tipos de doenças auto-imunes cujos sintomas se relacionam com o tipo de tecido que é atacado e destruído pelo sistema imunitário do próprio organismo. São exemplos de doenças auto-imunes: . Esclerose múltipla – linfócitos T destroem a mielina dos neurónios. Os sintomas incluem várias alterações neurológicas; . Artrite reumatóide – inflamação dolorosa das cartilagens articulares, que são destruídas; . Lúpus – o sistema imunitário produz anticorpos contra vários tipos de moléculas próprias, incluindo histonas e DNA. Caracteriza-se por erupções da pele, febre, artrite e disfunção renal; . Diabetes insulinodependentes – são destruídas as células do pâncreas que produzem insulina. Imunodeficiências As imunodeficiências podem ser inatas ou adquiridas. Imunodeficiência inata A maioria das imunodeficiências inatas afecta tanto a resposta humoral como a resposta celular e resultam de deficiências genéticas que se manifestam durante o desenvolvimento embrionário. Estas anomalias traduzem-se por malformações do timo, resultando numa produção insuficiente ou na total ausência de linfócitos (a falta de linfócitos T traduz numa maior sensibilidade a agentes infecciosos intracelulares, vírus e cancros e a falta de linfócitos B traduz-se numa maior sensibilidade a infecções extracelulares). Deste tipo de imunodeficiência temos a SCID (imunodeficiência grave combinada) que se caracteriza pela ausência de linfócitos B e T. Os doentes são extremamente vulneráveis e apenas sobrevivem em ambientes completamente estéreis (imagem pequenina da página 218). O transplante de medula óssea e/ou terapia genica são tratamentos da SCID. Imunodeficiência adquirida A imunodeficiência adquirida mais conhecida é, sem dúvidas, a SIDA. A SIDA é causada pelo vírus HIV que ataca certas células do organismo merecendo destaque alguns tipos de linfócitos T (Th) e os macrófagos. O HIV é um retrovírus, isto é, possui RNA como suporte da informação genética. Para poder introduzir os seus genes no DNA da célula a infectar, recorre à enzima transcriptase reversa, que transcreve o RNA para DNA. Esta molécula de DNA complementar é incorporada no DNA da célula hospedeira. O vírus pode manter-se inactivo durante períodos mais ou menos longos. Quando activo, o DNA viral dirige a produção de novos vírus que causam a destruição da célula hospedeira (lise celular) e infectam novas células, este vírus infecta principalmente os linfócitos Th, mas também outros linfócitos, macrófagos e células do sistema nervoso. A destruição progressiva de linfócitos T envolvidos na comunicação e estimulação de outras células do sistema imunitário impede a cooperação entre os diversos componentes deste sistema. A descoordenação do sistema imunitário torna o organismo vulnerável a diversas infecções oportunistas. Além disso, por vezes, proliferam células anormais, originando cancros. Assim, o individuo com SIDA pode sucumbir vítima de infecções oportunistas ou de cancros. Imagem da página 219 Os vírus que se encontram no interior das células infectadas escapam à acção dos anticorpos, o que é uma das razões para esta doença ainda não ter tratamento. Como já disse, não há cura nem vacina para a doença, mas a sua progressão pode ser retardada por drogas inibidoras da transcriptase reversa (AZT) e das proteases e inibidores da ligação do vírus às células hospedeiras. 2. Biotecnologia no Diagnóstico e na Terapêutica de DoençasA Biotecnologia ocupa-se da manipulação de organismos, células ou moléculas biológicas com aplicações específicas. O diagnóstico e a terapêutica de doenças constituem campos de aplicações da Biotecnologia, nomeadamente através da imunoterapia, que permite amplificar ou dirigir a resposta imunitária, e da produção de substâncias, como antibióticos, esteróides, vitaminas e vacinas. Os anticorpos, dada a sua elevada especificidade, podem ser biomedicamente utilizados: . Na identificação de antigénios específicos, mesmo quando presentes em quantidades muito pequenas; . No ataque “cirúrgico” a células que apresentam antigénio específico. Os anticorpos produzidos pelo organismo resultam da síntese efectuada por inúmeros plasmócitos, os quais são clones de diferentes linfócitos B. Pelo facto de estes anticorpos serem produtos de diferentes linhagens de células B, cada uma específica para um determinante antigénio distinto, são designados anticorpos policlonais. Antigamente, os anticorpos eram obtidos a partir do soro de animais que tinham sido previamente inoculados com o antigénio ou a partir do soro de uma pessoa que tivesse sido exposta a esse antigénio. Contudo, dada a diversidade molecular do seu conteúdo, este soro, tradicionalmente utilizado em processos de imunização passiva, envolve riscos de rejeição e ataque imunitário por parte do receptor. Em 1975, Milstein e Kohler, investigadores do Laboratório de Biologia Molecular de Cambridge, desenvolveram anticorpos idênticos, produzidos a partir da clonagem de um único linfócito B, sendo, por isso, designados anticorpos monoclonais. Estes investigadores sabiam que os anticorpos policlonais resultam da activação de diversos clones de linfócitos, após a exposição a um determinado antigénio (recorde-se que normalmente, um antigénio possui diversos determinantes antigénicos). Se após esta activação fosse isolado um único linfócito B, seria possível cloná-lo, produzindo, deste modo, várias células idênticas (e, portanto, produtoras de anticorpos iguais). Estes anticorpos teriam as vantagens de não necessitarem de serem submetidos ao processo de purificação e, sobretudo, de serem específicos para um determinado antigénio. Embora fosse possível isolar um linfócito B e produzir clones seus, permanecia impossível manter em cultura prolongada esses clones. Milstein e Kohler ultrapassaram esta dificuldade fundindo um linfócito B activado com uma célula tumoral do sistema imunitário, por vezes designado mieloma, que, por ser maligna, se divide indefinidamente. Desta fusão resultou uma nova célula chamada hibridoma, que reúne as características das células parentais: . Formam culturas celulares permanentes (característica da célula cancerosa). . Produzem anticorpos específicos para um só tipo de determinante antigénico (característica do linfócito B). Uma forma de produzir anticorpos monoclonais consiste na inoculação de ratos de laboratório com um antigénio. Após o inicio da produção de anticorpos para esse antigénio, procede-se à recolha de linfócitos B. A fusão destes linfócitos com mielomas é induzida in vitro por substâncias químicas, produzindo hibridomas. É então realizar uma selecção dos hibridomas. Aqueles que produzem o anticorpo pretendido são isolados e, após a sua clonagem, obtêm-se anticorpos monoclonais. Resumo do processo de Milstein e Kohler (anexos) Os anticorpos monoclonais têm inúmeras aplicações (página 229): . Diagnóstico de doenças ou condições clínicas – como testes de gravidez, diagnóstico de gonorreia, sífilis, hepatite, raiva, etc; . Imunização passiva – vacinas . Tratamento do cancro – associação a substâncias tóxicas ou radioactivas, com destruição das células cancerosas . Enxertos e transplantes – teste de compatibilidade . Antídotos – para venenos e drogas Além dos anticorpos monoclonais, diversos produtos têm sido desenvolvidos através de processos biotecnológicos, com importantes aplicações no diagnóstico e na terapêutica de doenças. Um desses processos é a bioconversão ou biotransformação. A bioconversão é a biotecnologia que recorre a microrganismos capazes de realizar certas reacções químicas de transformação de compostos estruturalmente semelhantes, com aplicações terapêuticas, produzidos em quantidades industriais e em condições mais favoráveis que a síntese química.
Bioconversão de esteróides (realizada por R. nigricans) A bioconversão tem-se mostrado vantajosa na obtenção de produtos relativamente aos processos de síntese química tradicional. Por exemplo: . Diminui o número de reacções necessárias para a obtenção do produto, tornando assim a sua produção mais rápida; . Permite realizar transformações, que seriam difíceis de efectuar por síntese química. Por exemplo, a bioconversão realizada por R. nigricans consiste numa oxidação que é extremamente difícil de conseguir por catálise química. . Devido à sua eficácia e diminuição do número de passos necessários para a obtenção dp produto, é, em muito casos, economicamente rentável. . Permite um aumento do grau de pureza/especificidade, com consequente diminuição do risco de alergias e efeitos secundários. Áreas em que a bioconversão é uma mais-valia:
Nota: algumas substâncias, como a penicilina, são posteriormente modificadas para se tornarem mais eficazes e para tornarem a sua administração mais prática. Lê página 231-232 Outros Trabalhos Relacionados
|
|